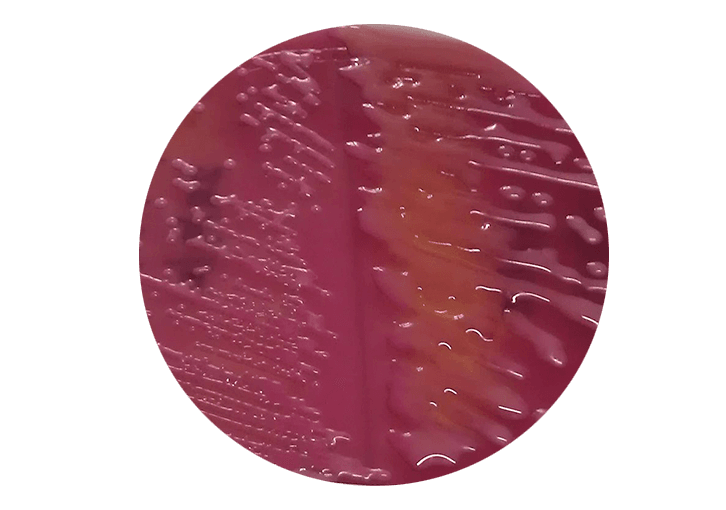

Blasenentzündung
masculine — Frauen / Frauenkrankheiten / Blase /
Die Zystitis
Blasenentzündung.
ICD-10: N34
Das Problem die Harnblasenentzündung
Zystitis, anders genannt Blasenentzündung, ist klassifiziert als einfache akute Zystitis oder langdauernde chronische Zystitis. Grampositive und gramnegative Bakterien, Viren und Pilze können die Ursache sein. Junge, sexuell aktive Frauen sind am häufigsten betroffen. Die Darmflora Escherichia coli (E. coli) ist für 77-95% der Fälle verantwortlich.
Die Ursache, warum manche Männer unter diesem sozial schwerwiegenden Problem leiden, liegt in:

© Bruce Mars / unsplash.com
Mikroorganismen der Zystitis
Bakterien
-
Grampositive Bakterien:
- Escherichia coli (E. coli)
- Proteus mirabilis
- Klebsiella pneumoniae
- Pseudomonas aeruginosa
- Neisseria Gonorrhoeae
- Chlamydia trachomatis
- Ureaplasma urealyticum
- Mykoplasma pneumonia
-
Grampositive Bakterien:
- Staphylococcus aureus
- Staphylococcus saprophyticus
Viren
- Adenoviren
Hefen
- Candida albicans
- Aspergillus aureus
Parasiten
- Schistosoma haematobium (Bilharziose)
Arten der Blasenentzündung:
- Bakteriell
- Virale
- Pilz
- Bilharzia
- Interstitielle
- Hämorrhagische (blutend)
- Strahlentherapie
- Chemotherapie
- Immuntherapie
Mikroorganismen und Bakterien, die in der Harnblase vorkommen
"Alle in diesem Slider verwendeten Bilder stammen aus der wissenschaftlichen Enzyklopädie Wikipedia."
Die begünstigten Faktoren sind von anatomischen Gegebenheiten, dem Verhalten und der Hygiene abhängig.
Die begünstigenden Faktoren der Zystitis:
- Kurze Harnröhre der Frau (1,5 cm lang)
- Anatomische Nähe der Harnröhre der Frau zu Vagina und After
- Häufiger Geschlechtsverkehr und damit verbundene
- mechanische Reibung
- Harnröhrenverengung
- Blasenkatheter
- Blasenmanipulation (Blasenspiegelung)
- Restharnbildung (Harnröhrenobstruktion, Divertikel,
- Reflux)
- Diabetes mellitus
- Abwehrschwäche
- Kälte
- Unhygienischer Sex
Ursachen des unhygienischen Sex:
- Drogen
- sporadischer Geschlechtsverkehr mit wechselnden Partnern
- Chem-Sex (Steigerung des sexuellen Erlebens durch Konsum von Drogen)
STD
sind durch
„safe Sex“(sicheren Geschlechtsverkehr) zu vermeiden.
Methoden
des „safe sex“:
- Ehe
- Gesunde feste Partner(in)
- Kondom
- Körperliche Hygiene
- Testgerechte Antibiotika, wenn erforderlich
- Gesundheitscheck
Der Übertragungsweg:
- Haut- und Schleimhautkontakt
- Ungeschützter Vaginal-, Anal- und Oralsex
- Schmierinfektion über Hände (Türgriffe, Toilette, Kleidung, Bettwäsche) und Sexspielzeug
- Sauna und feuchte Plätze
Der die Entzündung verursachende Mikroorganismus muss als Kultur isoliert und identifiziert werden, um testgerechte Antibiotika zu verabreichen. Nur so können Resistenz und die Entwicklung einer chronischen Zystitis vermieden werden. Weiterhin, sind Schutz von der Kälte und Bekämpfung der Ursachen wichtige Schritte, um dem Wiederkehren der Blasenentzündung vorzubeugen.
Die Symptome der Zystitis:
- Schmerzen in der Harnröhre
- Brennen bei der Miktion
- Erhöhte Miktionsfrequenz
- Harndrang
- Juckreiz in den Genitalien (Brennen im Schritt)
- Makrohämaturie (Blut im Urin)
- Fieber
die Blase und sein Aufbau
bladder — мочевой пузырь — 膀胱 — مثانة — Blase
Für wen ist dieser Behandlung indiziert?
Patienten die unter den o.g. Beschwerden leiden.
Der Behandlungsablauf
Eine Blasenentzündung bedarf präziser Diagnostik. Die Anamnese, das klinische Bild und eine Urinuntersuchung sind für die spezifische Diagnose erforderlich. Die Kultur des Erregers und ein Antibiotika-Test bieten die Möglichkeit für eine testgerechte Behandlung bei komplizierten wiederkehrenden Zystitiden. Eine Kontrolle mindestens 5 Tage nach Ende der Behandlung ist erforderlich, um sicher zu sein, dass die Behandlung vollständig ist. Weiterhin sind Harnröhren- bzw. vaginale Abstriche indiziert, wenn die Zystitiden sich wiederholen.
Was soll man vor der Behandlung der Blasenentzündung beachten?
Hygiene und Abstinenz von Geschlechtsverkehr. Geschützter Sex reicht nicht, um eine vollständige Heilung zu erzielen.
Die Implantation einer Manschette oder Ventil ist eine sichere Methode der Behandlung von Inkontinenz nach der radikalen Operation der Prostata.

© Dr. Aref Elseweifi / masculine.de
Wie wird die Behandlung durchgeführt?
Die Behandlung wird je nach der Ursache (Pathogen) wie folgt unterteilt:
Symptomatische Behandlung:
- Die Blasenwand-relaxierende Medikamente (Parasympathomemitika),
- Die Blasenschleimhaut bekleidende Medikamente (Glykosaminoglykan).
Prophylaktische (vorbeugende) Behandlung:
- Abstinenz von Sex mit fremden Partnern,
- Hygiene,
- Schutz vor Kälte.
Optimierende Medikamente:
- Immunisierende Medikamente bei wiederholte E. coli,
- Entzündung (Uro-Vaxom),
- Harnansäuernde Medikamente,
- D-Mannose,
- Preiselbeeren.
Definitive Behandlung:
- Erstlinien-Antibiotika,
- Spezifische Antibiotika,
- Parenterale (in die Vene) Infusionen und Spritzen (in schweren Fällen),
- Parallele Behandlung der Partnerin bzw. des Partners.
Metaphylaktische (nachhaltende) Behandlung:
- Entfernung von der Entzündungsquelle,
- Geschlechtsverkehr nur mit einem einzigen Partner,
- Hygiene,
- Wärme.
empty
Wie lange dauert die Behandlung der Blasenentzündung?
Wie lange dauert die Heilungsphase?
Wie lange besteht Arbeitsunfähigkeit?
Welche Einschränkungen (Narben, Schwellungen, usw.) bringt die Behandlung der akuten Zystitis mit sich?
Sie können Ihre Operation über medipay finanzieren.
Informieren Sie sich jetzt: 0 22 41 / 96 9 26-0
Operation auf einen Blick
Blasenentzündung
Operation
| : Genesung | |
|---|---|
| : Operation Dauer | |
| : Narkose |
Vor und Nachsorge
| : Vorbereitung | |
|---|---|
| : Ausfallzeit | |
| : Nachsorge | |
| : Sexuelle Aktivität | |
| : Sport & Sonnenbaden | |
| : Termin | |
| : Betreuung am Heimatort |
Kosten
| Privatversicherung: | Wird nach GOÄ je Schweregrad der Operation berechnet. |
|---|---|
| Selbstzahler | |
| : Operation | |
| : Narkose | |
| allgemeine | 380 €* je angefangene Stunde. |
| örtliche | 250 €* je angefangene Stunde. |
| : Übernachtung | 300 €* |
| Eine Ratenzahlung ist möglich. Wir arbeiten mit dem Finanzierungspartner Medipay zusammen. Sprechen Sie uns an. | |
| Kassenversicherung: | keine zusätzliche Zahlung. |
| 100 €* Stornierungsgebühr bei Absage bis 2 Wochen vor OP bzw. |
* Alle Preise sind Nettoangaben und verstehen sich zzgl. der gesetzlichen Mehrwertsteuer. |
|---|---|
| 500 €* Gebühr bei Absage unter 2 Wochen vor OP° |
° Die Stornierungsgebühren werden wegen des administrativen Aufwands erhoben. Die Rechnungen werden für absolute Transparenz nach der Gebührenordnung für Ärzte (GOÄ) auch mit analogen Ziffern erstellt, falls erforderlich. |
masculine — — Praxis für Urologie
Nachsorge
Die Erwartungen nach der Behandlung der Blasenentzündung
Wann wird das Endergebnis der Behandlung sichtbar sein?
Schon 3-7 Tage nach Einnahme der Antibiotika werden die Symptome deutlich verringert.
Wie lange hält das Ergebnis an?
Das Ergebnis ist dauerhaft, solange die Entzündungsquelle entfernt bleibt. Die Prophylaxe und Metaphylaxe sind wichtig für eine dauerhafte Freiheit von Symptomen.

© Allen Taylor / unsplash.com
Komplikationen
der Behandlung der Blasenentzündung
H3: Welche Probleme können auftreten?
Was sollte nach der Zystitis Behandlung vermieden werden?
Welche Komplikationen können während der Heilungsphase auftreten?
Mögliche Komplikationen sind:
- Ausbreitung der Entzündung,
- Chronische Entzündung,
- Harndrang,
- Ziehende Schmerzen,
- Schwacher Harnstrahl.
Wie können Sie die Heilung beschleunigen?
Es ist so ratsamer |
|||
|---|---|---|---|
|
Ein Antibiotikum bis zu 10 Tage lang einzunehmen. Den Verband für 10 Tage nach der Operation täglich zu wechseln. |
|||
|
Baden und Schwimmen |
|||
Because health is life – FAQ—Nachsorge |
|||
Sie können die eventuellen Komplikationen Ihre Operation durch engmaschige postoperative Kontrolle bei Ihrem Arzt vermeiden.
Kontraindikationen
Was sind Kontraindikationen bei Blasenentzündung?
In welchen Fällen kann der Behandlung der Blasenentzündung nicht durchgeführt werden?
Keine
© Rawpixel / unsplash.com
Die Blasenentzündung
auf einen Blick
Zusammenfassung und Schlusswort von Dr.med. Elseweifi
Abwägung der Risiken, Vorteile und Nachteile der Behandlung die Blasenentzündung
Akute Zystitis kann durch verschiedene Erreger verursacht werden. Sie ist direkt oder indirekt übertragbar. Sie verursacht Schmerzen, Blasenfunktionsstörung, Brennen bei der Miktion, Blut im Urin oder Fieber. Sie hat in den letzten 10 Jahren durch jugendliches unverantwortliches Verhalten zugenommen. Die Behandlung beruht auf präziser Diagnose der Erreger, testgerechten Medikamenten, Wärme, Flüssigkeitszufuhr und Hygiene. Die Entwicklung von chronischen Schmerzen, chronischer Zystitis, sind mögliche Folgen, wenn die Behandlung vernachlässigt wird. Das Vermeiden von Sex mit fremden Partnern und Kälte sowie Hygiene sind die besten Methoden, um eine Zystitis zu vermeiden. Interstitielle Zystitis muss mit einem Medikament, das die Schleimhaut bekleidet, behandelt werden. Weiterhin müssen Medikamente gegen die Symptome verabreicht werden. Vorbeugungsmaßnahmen sind D-Mannose, und Preiselbeerenextrakte. Die Verabreichung von L-Methionin dient dazu, das pH des Urins anzusäuern, um das Bakterienwachstum zu hemmen und die Wirkung des Antibiotikums zu optimieren.
Gibt es alternativen Behandlung mit dem gleichen Effekt?
Eine Alternative gibt es bisher nicht.
Die Implantation einer Manschette oder Ventil ist eine sichere Methode der Behandlung von Inkontinenz nach der radikalen Operation der Prostata.
Quelle
Blasenentzündung
bladder — мочевой пузырь — 膀胱 — مثانة — Blase